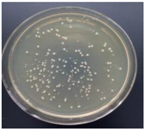
Materials 11 00323 i001
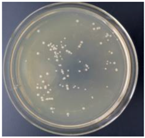
Materials 11 00323 i003
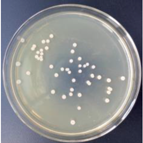
Materials 11 00323 i004
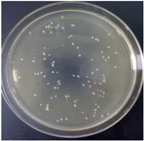
Materials 11 00323 i005
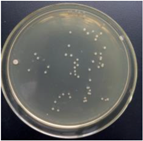
Materials 11 00323 i007
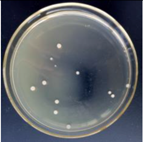
Materials 11 00323 i008
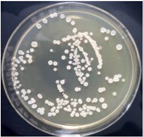
Materials 11 00323 i012
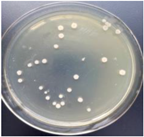
Materials 11 00323 i016
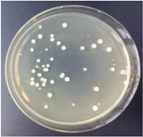
Materials 11 00323 i018
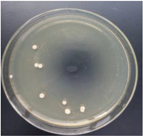
Materials 11 00323 i020

The Preparation, Characterization, Mechanical and Antibacterial Properties of GO-ZnO Nanocomposites with a Poly(l-lactide)-Modified Surface
Abstract
:1. Introduction
2. Materials and Methods
2.1. Materials
2.1.1. Preparation of Raw Materials
2.1.2. Preparation of GO-ZnO-PLLA
2.1.3. Preparation of the Composite Material GO-ZnO-PLLA/PLLA
2.1.4. Preparation of the GO-ZnO-PLLA/PLLA Composite Film
3. Results and Discussion
3.1. Characterization of GO-ZnO-PLLA
3.2. GO-ZnO-PLLA Molecular Weight Measurement (Using GPC)
3.3. X-ray Photoelectron Spectroscopy (XPS) Analysis of GO-ZnO-PLLA
3.4. Infrared (IR) Spectroscopy
3.5. Differential Scanning Calorimetry (DSC) of PLLA and Its Composites
3.6. Thermogravimetric Analysis (TGA)
3.7. Physical Property Characterization
3.8. Dispersions of GO-ZnO–PLLA and GO-ZnO/PLLA in Chloroform
3.9. Testing of Tensile Properties of PLLA and GO-ZnO-PLLA/PLLA Composite Films
3.10. SEM Analysis of GO-ZnO-PLLA/PLLA
3.11. XRD Analysis of the GO-ZnO-PLLA/PLLA Composite Film
3.12. Test of the Antibacterial Properties of GO-ZnO-PLLA/PLLA Composite Film
4. Conclusions
Acknowledgments
Author Contributions
Conflicts of Interest
References
- Ray, S.S.; Bousmina, M. Biodegradable polymers and their layered silicate nano composites: In greening the 21st century materials world. Prog. Mater. Sci. 2005, 50, 962–1079. [Google Scholar]
- Lagaron, J.M.; Lopez-Rubio, A. Nanotechnology for bioplastics: Opportunities, challenges and strategies. Trends Food Sci. Technol. 2011, 22, 611–617. [Google Scholar] [CrossRef]
- Gorrasi, G.; Pantani, R.; Murariu, M.; Dubois, P. PLA/Halloysite nanocomposite films: Water vapor barrier properties and specific key characteristics. Macromol. Mater. Eng. 2014, 299, 104–115. [Google Scholar] [CrossRef]
- Sanchez Reig, C.; Dobon Lopez, A.; Hortal Ramos, M.; Cloquell Ballester, V.A. Nanomaterials: A map for their selection in food packaging applications. Packag. Technol. Sci. 2014, 27, 839–866. [Google Scholar] [CrossRef]
- Guillard, V.; Mauricio-Iglesias, M.; Gontard, N. Effect of novel food processing methods on packaging: Structure, composition, and migration properties. Crit. Rev. Food Sci. Nutr. 2010, 50, 969–988. [Google Scholar] [CrossRef] [PubMed]
- Tang, X.Z.; Kumar, P.; Alavi, S.; Sandeep, K.P. Recent advances in biopolymers and biopolymer-based nanocomposites for food packaging materials. Crit. Rev. Food Sci. Nutr. 2012, 52, 426–442. [Google Scholar] [CrossRef] [PubMed]
- Murariu, M.; Doumbia, A.; Bonnaud, L.; Dechief, A.-L.; Paint, Y.; Ferreira, M.; Campagne, C.; Devaux, E.; Dubois, P. High-performance Polylactide/ZnO nanocomposites designed for films and fibers with special end-use properties. Biomacromolecules 2011, 12, 1762–1771. [Google Scholar] [CrossRef] [PubMed]
- Huang, Y.; Wang, T.; Zhao, X.; Wang, X.; Zhou, L.; Yang, Y.; Liao, F.; Ju, Y. Poly(lactic acid)/graphene oxide-ZnO nanocomposite films with good mechanical, dynamic mechanical, anti-UV and antibacterial properties. J. Chem. Technol. Biotechnol. 2015, 90, 1677–1684. [Google Scholar] [CrossRef]
- Fan, W.; Zhao, Y.; Zhang, A.; Liu, Y.; Cao, Y.; Chen, J. Effect of a Chain Extender on the Properties of Poly(lactic acid)/Zinc Oxide/Copper Chlorophyll Acid Antibacterial Nanocomposites. J. Appl. Polym. Sci. 2015, 132. [Google Scholar] [CrossRef]
- Murariu, M.; Paint, Y.; Murariu, O.; Raquez, J.-M.; Bonnaud, L.; Dubois, P. Current progress in the production of PLA-ZnO nanocomposites: Beneficial effects of chain extender addition on key properties. J. Appl. Polym. Sci. 2015, 132. [Google Scholar] [CrossRef]
- Xu, J.-Z.; Chen, T.; Yang, C.-L.; Li, Z.-M.; Mao, Y.-M.; Zeng, B.-Q.; Hsiao, B.S. Isothermal crystallization of Poly(l-lactide) induced by graphene nanosheets and carbon nanotubes: A comparative study. Macromolecules 2010, 43, 5000–5008. [Google Scholar] [CrossRef]
- Murariu, M.; Dechief, A.L.; Bonnaud, L.; Paint, Y.; Gallos, A.; Fontaine, G.; Bourbigot, S.; Dubois, P. The production and properties of polylactide composites filled with expanded graphite. Polym. Degrad. Stab. 2010, 95, 889–900. [Google Scholar] [CrossRef]
- Cao, Y.; Feng, J.; Wu, P. Preparation of organically dispersible graphene nanosheet powders through a lyophilization method and their poly(lactic acid) composites. Carbon 2010, 48, 3834–3839. [Google Scholar] [CrossRef]
- Wang, H.; Qiu, Z. Crystallization behaviors of biodegradable poly(l-lactic acid)/graphene oxide nanocomposites from the amorphous state. Thermochim. Acta 2011, 526, 229–236. [Google Scholar] [CrossRef]
- Xie, M.; Lei, H.; Zhang, Y.; Xu, Y.; Shen, S.; Ge, Y.; Li, H.; Xie, J. Non-covalent modification of graphene oxide nanocomposites with chitosan/dextran and its application in drug delivery. RSC Adv. 2016, 6, 9328–9337. [Google Scholar] [CrossRef]
- Liu, S.; Gordiichuk, P.; Wu, Z.-S.; Liu, Z.; Wei, W.; Wagner, M.; Mohamed-Noriega, N.; Wu, D.; Mai, Y.; Herrmann, A.; et al. Patterning two-dimensional free-standing surfaces with mesoporous conducting polymers. Nat. Commun. 2015, 6, 8817. [Google Scholar] [CrossRef] [PubMed]
- Liu, S.; Zhang, J.; Dong, R.; Gordiichuk, P.; Zhang, T.; Zhuang, X.; Mai, Y.; Liu, F.; Herrmann, A.; Feng, X. Two-dimensional mesoscale-ordered conducting polymers. Angew. Chem.-Int. Ed. 2016, 55, 12516–12521. [Google Scholar] [CrossRef] [PubMed]
- Posa, V.R.; Annavaram, V.; Koduru, J.R.; Ammireddy, V.R.; Somala, A.R. Graphene-ZnO nanocomposite for highly efficient photocatalytic degradation of methyl orange dye under solar light irradiation. Korean J. Chem. Eng. 2016, 33, 456–464. [Google Scholar] [CrossRef]
- Yuan, M.L.; Li, X.H.; Xiong, C.D.; Deng, X.M. Polymerization of lactides and lactones 5. Ring-opening polymerization of epsilon-caprolactone and dl-lactide by rare earth 2-methylphenyl samarium. Eur. Polym. J. 1999, 35, 2131–2138. [Google Scholar] [CrossRef]
- Deng, X.M.; Yuan, M.L.; Xiong, C.D.; Li, X.H. Polymerization of lactides and lactones. II. Ring-opening polymerization of epsilon-caprolactone and dl-lactide by organoacid rare earth compounds. J. Appl. Polym. Sci. 1999, 71, 1941–1948. [Google Scholar] [CrossRef]
- Yuan, M.L.; Xiong, C.D.; Li, X.H.; Deng, X.M. Polymerization of lactides and lactones. III. Ring-opening polymerization of dl-lactide by the (η3-C3H5)2Sm(μ2-Cl)2(μ3-Cl)2Mg(tmed)(μ2-Cl)Mg(tmed) complex. J. Appl. Polym. Sci. 1999, 73, 2857–2862. [Google Scholar] [CrossRef]
- Deng, X.M.; Yuan, M.L.; Xiong, C.D.; Li, X.H. Polymerization of lactides and lactones. IV. Ring-opening polymerization of epsilon-caprolactone by rare earth phenyl compounds. J. Appl. Polym. Sci. 1999, 73, 1401–1408. [Google Scholar] [CrossRef]
- Deng, X.M.; Yuan, M.L.; Li, X.H.; Xiong, C.D. Polymerization of lactides and lactones VII. Ring-opening polymerization of lactide by rare earth phenyl compounds. Eur. Polym. J. 2000, 36, 1151–1156. [Google Scholar] [CrossRef]
- Yuan, M.L.; Wang, Y.H.; Li, X.H.; Xiong, C.D.; Deng, X.M. Polymerization of lactides and lactones. 10. Synthesis, characterization, and application of amino-terminated poly(ethylene glycol)-co-poly(epsilon-caprolactone) block copolymer. Macromolecules 2000, 33, 1613–1617. [Google Scholar] [CrossRef]
- Hua, L.; Kai, W.; Yang, J.; Inoue, Y. A new poly(l-lactide)-grafted graphite oxide composite: Facile synthesis, electrical properties and crystallization behaviors. Polym. Degrad. Stab. 2010, 95, 2619–2627. [Google Scholar] [CrossRef]
- Song, W.; Zheng, Z.; Tang, W.; Wang, X. A facile approach to covalently functionalized carbon nanotubes with biocompatible polymer. Polymer 2007, 48, 3658–3663. [Google Scholar] [CrossRef]
- Yoon, J.T.; Lee, S.C.; Jeong, Y.G. Effects of grafted chain length on mechanical and electrical properties of nanocomposites containing polylactide-grafted carbon nanotubes. Compos. Sci. Technol. 2010, 70, 776–782. [Google Scholar] [CrossRef]
- Sun, Y.; He, C. Synthesis and Stereocomplex Crystallization of Poly(lactide)-Graphene Oxide Nanocomposites. ACS Macro Lett. 2012, 1, 709–713. [Google Scholar] [CrossRef]
- Goffin, A.-L.; Raquez, J.-M.; Duquesne, E.; Siqueira, G.; Habibi, Y.; Dufresne, A.; Dubois, P. From interfacial ring-opening polymerization to melt processing of cellulose nanowhisker-filled polylactide-based nanocomposites. Biomacromolecules 2011, 12, 2456–2465. [Google Scholar] [CrossRef] [PubMed]
- Yoon, J.T.; Jeong, Y.G.; Lee, S.C.; Min, B.G. Influences of poly(lactic acid)-grafted carbon nanotube on thermal, mechanical, and electrical properties of poly(lactic acid). Polym. Adv. Technol. 2009, 20, 631–638. [Google Scholar] [CrossRef]
- Amirian, M.; Chakoli, A.N.; Sui, J.H.; Cai, W. Enhanced mechanical and photoluminescence effect of poly(l-lactide) reinforced with functionalized multiwalled carbon nanotubes. Polym. Bull. 2012, 68, 1747–1763. [Google Scholar] [CrossRef]
- Olalde, B.; Aizpurua, J.M.; Garcia, A.; Bustero, I.; Obieta, I.; Jurado, M.J. Single-walled carbon nanotubes and multiwalled carbon nanotubes functionalized with poly(l-lactic acid): A comparative study. J. Phys. Chem. C 2008, 112, 10663–10667. [Google Scholar] [CrossRef]
- Chen, G.X.; Kim, H.S.; Park, B.H.; Yoon, J.S. Controlled functionalization of multiwalled carbon nanotubes with various molecular-weight poly(l-lactic acid). J. Phys. Chem. B 2005, 109, 22237–22243. [Google Scholar] [CrossRef] [PubMed]
- Chen, L.; Xu, Z.; Li, J.; Li, Y.; Shan, M.; Wang, C.; Wang, Z.; Guo, Q.; Liu, L.; Chen, G.; et al. A facile strategy to prepare functionalized graphene via intercalation, grafting and self-exfoliation of graphite oxide. J. Mater. Chem. 2012, 22, 13460–13463. [Google Scholar] [CrossRef]
- Yang, J.-H.; Lin, S.-H.; Lee, Y.-D. Preparation and characterization of poly(l-lactide)-graphene composites using the in situ ring-opening polymerization of PLLA with graphene as the initiator. J. Mater. Chem. 2012, 22, 10805–10815. [Google Scholar] [CrossRef]
- Shen, J.; Hu, Y.; Shi, M.; Lu, X.; Qin, C.; Li, C.; Ye, M. Fast and Facile Preparation of Graphene Oxide and Reduced Graphene Oxide Nanoplatelets. Chem. Mater. 2009, 21, 3514–3520. [Google Scholar] [CrossRef]
- Li, W.; Xu, Z.; Chen, L.; Shan, M.; Tian, X.; Yang, C.; Lv, H.; Qian, X. A facile method to produce graphene oxide-g-poly(l-lactic acid) as an promising reinforcement for PLLA nanocomposites. Chem. Eng. J. 2014, 237, 291–299. [Google Scholar] [CrossRef]
- Cao, A.; Liu, Z.; Chu, S.; Wu, M.; Ye, Z.; Cai, Z.; Chang, Y.; Wang, S.; Gong, Q.; Liu, Y. A facile one-step method to poduce graphene-CdS quantum dot nanocomposites as promising optoelectronic materials. Adv. Mater. 2010, 22, 103–106. [Google Scholar] [CrossRef] [PubMed]
- Suk, J.W.; Piner, R.D.; An, J.; Ruoff, R.S. Mechanical Properties of Mono layer Graphene Oxide. ACS Nano 2010, 4, 6557–6564. [Google Scholar] [CrossRef] [PubMed]
- Ramanathan, T.; Abdala, A.A.; Stankovich, S.; Dikin, D.A.; Herrera-Alonso, M.; Piner, R.D.; Adamson, D.H.; Schniepp, H.C.; Chen, X.; Ruoff, R.S.; et al. Functionalized graphene sheets for polymer nanocomposites. Nat. Nanotechnol. 2008, 3, 327–331. [Google Scholar] [CrossRef] [PubMed]
- Sengupta, R.; Bhattacharya, M.; Bandyopadhyay, S.; Bhowmick, A.K. A review on the mechanical and electrical properties of graphite and modified graphite reinforced polymer composites. Prog. Polym. Sci. 2011, 36, 638–670. [Google Scholar] [CrossRef]
- Chieng, B.W.; Ibrahim, N.A.; Yunus, W.M.Z.W.; Hussein, M.Z.; Silverajah, V.S.G. Graphene nanoplatelets as novel reinforcement filler in Poly(lactic acid)/epoxidized palm oil green nanocomposites: Mechanical properties. Int. J. Mol. Sci. 2012, 13, 10920–10934. [Google Scholar] [CrossRef] [PubMed]
- Zhu, J.; Zeng, G.; Nie, F.; Xu, X.; Chen, S.; Han, Q.; Wang, X. Decorating graphene oxide with CuO nanoparticles in a water-isopropanol system. Nanoscale 2010, 2, 988–994. [Google Scholar] [CrossRef] [PubMed]
- Yang, Y.; Ren, L.; Zhang, C.; Huang, S.; Liu, T. Facile fabrication of functionalized graphene sheets (FGS)/ZnO nanocomposites with photocatalytic property. ACS Appl. Mater. Interfaces 2011, 3, 2779–2785. [Google Scholar] [CrossRef] [PubMed]
- Zhou, X.; Shi, T.; Zhou, H. Hydrothermal preparation of ZnO-reduced graphene oxide hybrid with high performance in photocatalytic degradation. Appl. Surf. Sci. 2012, 258, 6204–6211. [Google Scholar] [CrossRef]
- Wang, X.; Zhou, N.; Yuan, J.; Wang, W.; Tang, Y.; Lu, C.; Zhang, J.; Shen, J. Antibacterial and anticoagulation properties of carboxylated graphene oxide-lanthanum complexes. J. Mater. Chem. 2012, 22, 1673–1678. [Google Scholar] [CrossRef]














| Mn | Mw | MP | Mz | Mz + 1 | Polydispersity (Mw/Mn) | Mz/Mw |
|---|---|---|---|---|---|---|
| 15,784 | 17,362 | 17,409 | 18,912 | 20,584 | 1.099972 | 1.08925 |
| Sample Name | Elastic Modulus (MPa) | Elongation at Break (%) | Tensile Stress at Break (MPa) | Tensile Strength (MPa) |
|---|---|---|---|---|
| PLLA | 1356.6 | 6.3 | 68.12 | 68.12 |
| (0.5%) GO-ZnO-PLLA/PLLA | 1405.58 | 7.42 | 66.83 | 72.94 |
| (1.0%) GO-ZnO-PLLA/PLLA | 1668.62 | 6.86 | 77.49 | 77.65 |
| (1.5%) GO-ZnO-PLLA/PLLA | 1730.62 | 9.8 | 86.24 | 86.24 |
| Samples | Staphylococcus aureus (S. aureus) | - | Escherichia coli (E. coli) | - |
|---|---|---|---|---|
| - | Colony Photo | Antibacterial Rate R/% | Colony Photo | Antibacterial Rate R/% |
| PLLA | | - |  | - |
| 0.5% GO-ZnO-PLLA | | 29.4 ± 5.3 | | 12.9 ± 4.7 |
| 1% GO-ZnO-PLLA | | 45.7 ± 2.3 |  | 32.9 ± 8.1 |
| 1.5% GO-ZnO-PLLA | | 58.9 ± 3.9 | | 54.1 ± 5.1 |
| 5% GO-ZnO-PLLA |  | 78.5 ± 6.8 |  | 75.3 ± 1.3 |
| Sample | Staphylococcus aureus (S. aureus) | - | Escherichia coli (E. coli) | - |
|---|---|---|---|---|
| - | Colony Photo | Antibacterial Rate R/% | Colony Photo | Antibacterial Rate R/% |
| PLLA |  | - | | - |
| 0.5% GO-ZnO-PLLA |  | 10.7 ± 5.9 |  | 17.1 ± 5.2 |
| 1% GO-ZnO-PLLA |  | 34.5 ± 5.5 | | 12.4 ± 4.8 |
| 1.5% GO-ZnO-PLLA |  | 42.1 ± 7.9 | | 43.3 ± 4.5 |
| 5% GO-ZnO-PLLA |  | 77.2 ± 2.8 | | 76.1 ± 0.9 |
© 2018 by the authors. Licensee MDPI, Basel, Switzerland. This article is an open access article distributed under the terms and conditions of the Creative Commons Attribution (CC BY) license (http://creativecommons.org/licenses/by/4.0/).
Share and Cite
Yuan, M.; Xiong, C.; Jiang, L.; Li, H.; Yuan, M. The Preparation, Characterization, Mechanical and Antibacterial Properties of GO-ZnO Nanocomposites with a Poly(l-lactide)-Modified Surface. Materials 2018, 11, 323. https://doi.org/10.3390/ma11020323
Yuan M, Xiong C, Jiang L, Li H, Yuan M. The Preparation, Characterization, Mechanical and Antibacterial Properties of GO-ZnO Nanocomposites with a Poly(l-lactide)-Modified Surface. Materials. 2018; 11(2):323. https://doi.org/10.3390/ma11020323
Chicago/Turabian StyleYuan, Mingwei, Chengdong Xiong, Lin Jiang, Hongli Li, and Minglong Yuan. 2018. "The Preparation, Characterization, Mechanical and Antibacterial Properties of GO-ZnO Nanocomposites with a Poly(l-lactide)-Modified Surface" Materials 11, no. 2: 323. https://doi.org/10.3390/ma11020323





